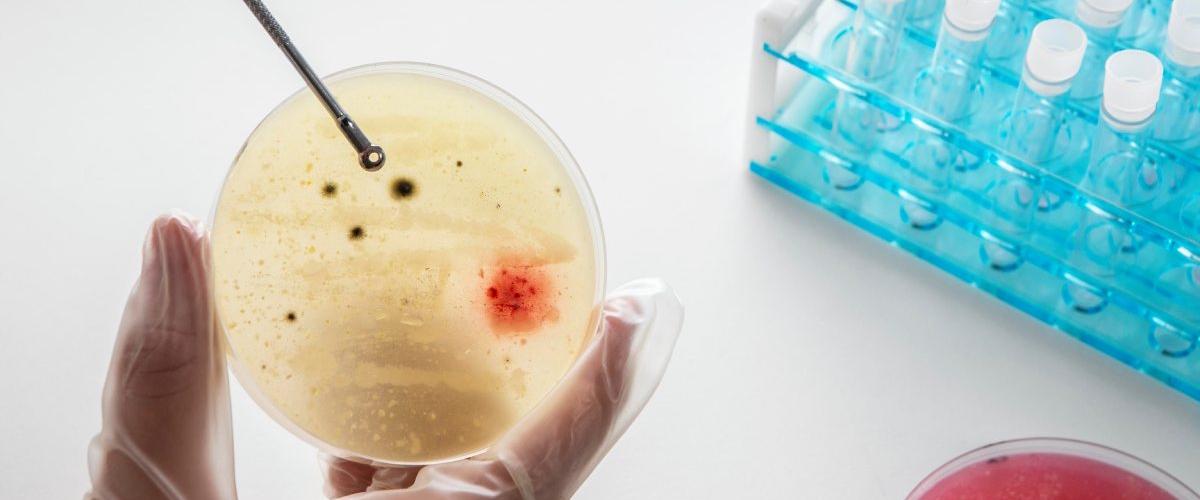
TODO:

При обнаружении рака мочевого пузыря на ранней стадии пятилетняя выживаемость составляет более 80%, однако именно на начальном этапе симптомы болезни часто путают с другими проблемами. Например, примерно у 85% пациентов наблюдается кровь в моче (гематурия), однако только в 5-20% случаев людей обследует на рак мочевого пузыря. Основная причина в инвазивности и сложности такой диагностики.
Чтобы упросить процесс обследования ученые из Южной Кореи использовали биомакер аберрантного метилирования PENK, который ранее показал высокую корреляцию с опухолью мочевого пузыря, пишет Elsevier. Идентификация PENK в моче показала 84% чувствительность и почти 96% специфичность у пациентов на всех стадиях.
«Удивительно, что тест на PENK был равен и даже превосходил по точности тесты на множественные биомаркеры», — комментируют ученые. По их словам, внедрение теста в клиническую практику должно значительно снизить смертность и медицинские расходы — опухоль мочевого пузыря входит в число самых дорогих типов рака из-за стоимости лечения.
В настоящее время планируется проведение более крупных клинических исследований, которые станут необходимой доказательной базой для одобрения теста.
Ранее другие исследователи представили тест на риски рака мочевого пузыря. Результаты с высокой точностью доступны за 10-12 лет до постановки диагноза.